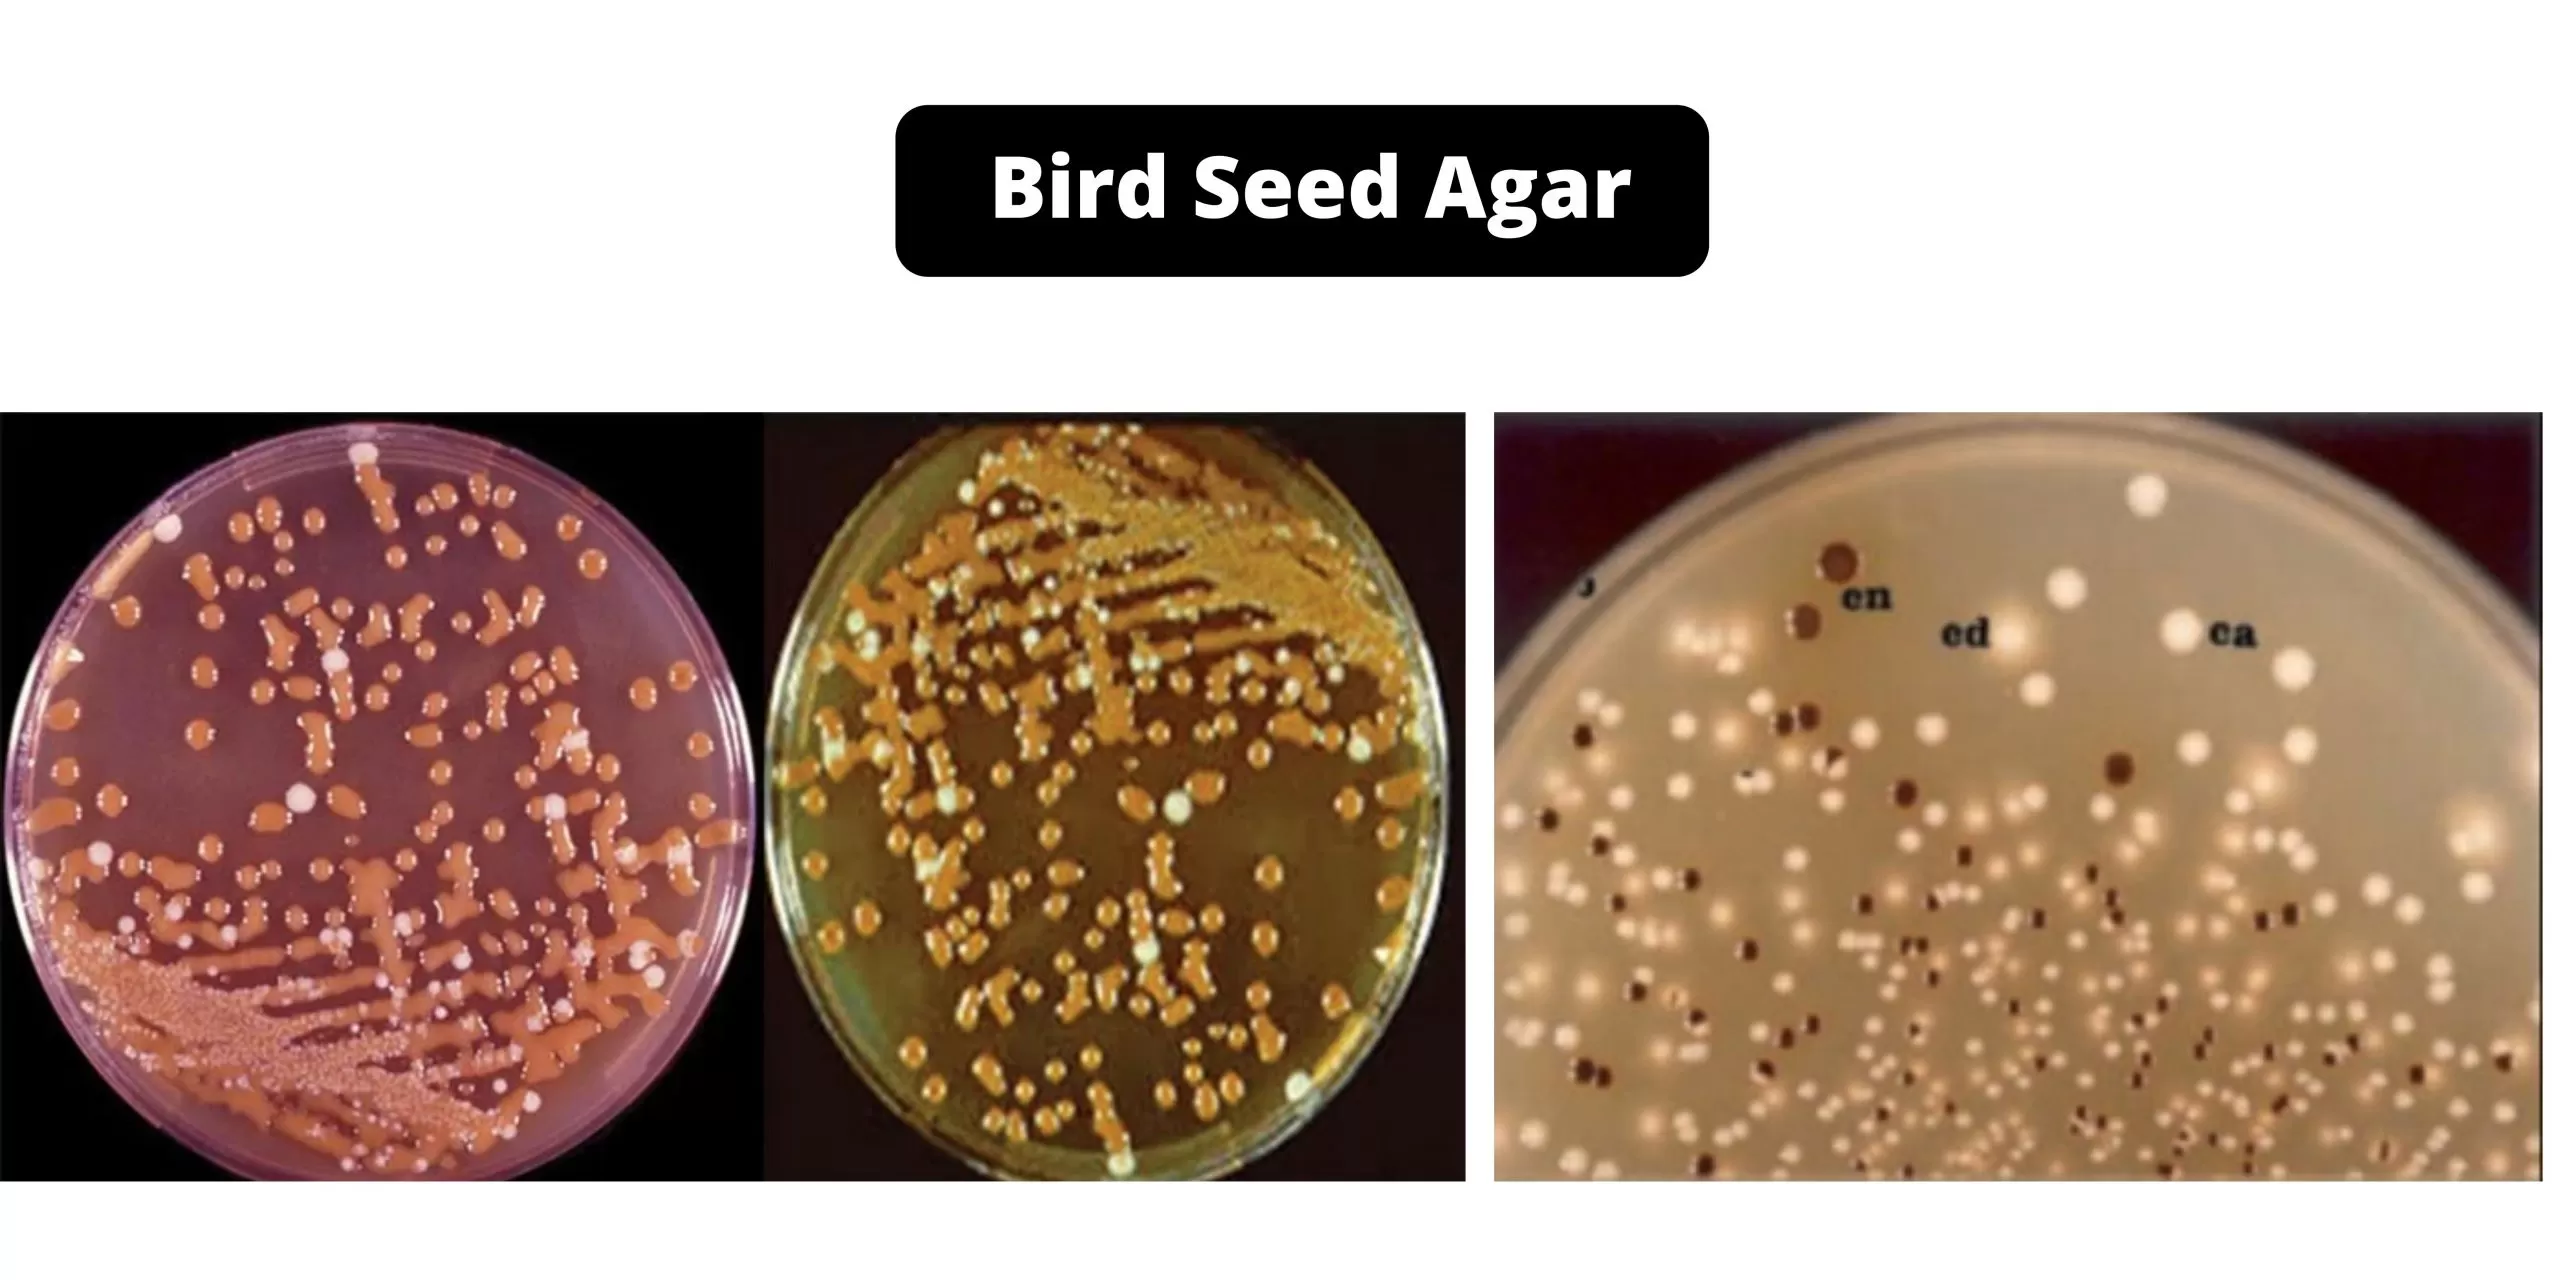
آگار bird seed

زیستگاه کریپتوکوکوس نئوفرمانس
- کریپتوکوکوس نئوفرمانس یک قارچ کپسوله شده محیطی است که در همه جا وجود دارد.
- این قارچ به وفور در خاک زندگی میکند و در فضولات پرندگان یافت میشود.
- در طبیعت، neoformans var. gattii (سروتیپهای B و C ) از چوب در حال پوسیدگی در درختان اکالیپتوس جدا شده است.
- neoformans var. neoformans (سروتیپ A و D ) اغلب از خاک آلوده به فضولات کبوتر یا سایر پرندگان جدا شده است.
- این قارچ همچنین از تودههای خشک شده قدیمی فضولات پرندگان در ساختمانها برداشت شده است، اما در فضولات مرطوب تازه یافت نشده است.
مورفولوژی کریپتوکوکوس نئوفرمانس
- نئوفرمانس یک مخمر محصور شده و محیطی است.
- کریپتوکوکوس نئوفورمانس مخمری گرد یا بیضیشکل به قطر 4 تا 6 میکرومتر است که توسط کپسولی با ضخامت 30 میکرومتر احاطه شده است.
- قارچ کروی که با جوانه زدن در هر نقطه از سطح تکثیر میشود، گاهی اوقات چندین جوانه را به طور همزمان در نقاط مختلف تولید میکند.
- جوانهها توسط یک دیواره نازک و یک منفذ بسیار باریک به سلول مادر متصل میشوند.
- در شرایط رشد سریع، جوانهها زودتر از سلول مادر جدا میشوند و سلولهای موجود در بافت و کشت به طور گستردهای از قطر 4 تا 20 میکرومتر متغیر هستند.
- دیواره سلولی نازک، در اثر خشک شدن یا تغییر ناگهانی فشار اسمزی فرومیریزد.
- سلول توسط کپسول پلیساکارید مخاطی احاطه شده است که یا نازک بوده یا برابر با ضخامت دوبرابر شعاع سلولی است.
- ضخامت کپسول با فشار قارچ متفاوت است و در بافت بیشتر از کشت است.
- تولید کپسول با رشد محلول پپتون 1 درصد افزایش یافت.
- چرخه زندگی شامل 2 شکل مختلف است: غیرجنسی و جنسی
- اشکال غیرجنسی (هاپلوئید و تکسلولی) به صورت سلولهای مخمر وجود دارند و با جوانه زدن تکثیر میشوند.
- چرخه جنسی توسط موارد زیر نشان داده میشود:
- ترکیب دو سلول مخمر
- تولید هیفهای بلند با اتصالات گیرهای
- تشکیل بازیدیوم
- بازیدیا با جوانه زدن مکرر، بازیدیوسپورها را تولید میکند که منجر به ایجاد زنجیرهای از بازیدیوسپورها میشود.

ویژگیهای کشت
- نئوفورمانس را میتوان بر روی انواع آگار کشت داد.
- SDA: کلنیها صاف، موکوئیدی و مخمر مانند به رنگ کرم.
- کشت پلیت دالمائو ( Dalmau Plate Culture):فقط سلولهای مخمر جوانهزده. هیچ شبه هیفی وجود ندارد.
- آگار بذر پرنده (Bird Seed Agar): کلنیها به رنگ قهوهای تیره ظاهر میشوند؛ زیرا کلنیها به طور انتخابی رنگدانه قهوهای را از محیط جذب میکنند.
- کاناوانین گلایسین برموتیمول بلو آگار (CGB): بدون رشد یا تغییر رنگ.
- کراتینین دکستروز بروموتیمول بلو تیمین آگار (CDBT): برای تشخیص و افتراق neoformans var. neoformans و neoformans var. grubii استفاده میشود.
- neoformans var. neoformans به صورت کلنیهای قرمز روشن رشد میکند و پس از 5 روز رنگ محیط را به نارنجی روشن تبدیل میکند درحالیکه هیچ تغییر رنگی برای neoformansvar. grubii مشاهده نمیشود.
مطالب مرتبط:
- آگار Bird Seed برای جداسازی کریپتوکوکوس نئوفورمانس
- سابورو دکستروز آگار (SDA): ترکیب، اساس، کاربرد، تهیه و مورفولوژی کلنی
اپیدمیولوژی کریپتوکوکوس نئوفرمانس
بر اساس تفاوت در تعدادی از خصوصیات قارچی، بیوشیمیایی، اکولوژیکی و اپیدمیولوژیک، سویههای نئوفرمانس را میتوان به دو گونه تقسیم کرد؛
- neoformans var. neoformans
- C. neoformans var. gattii
سویههای نئوفورمانس را همچنین میتوان به پنج سروتیپ A، B، C، D و AD تقسیم کرد. ( در AD هر دو عامل A و D موجود هستند) این تقسیم بندی بر اساس تفاوتهای آنتی ژنی بین پلیساکاریدهای کپسولی آنها است.
- دو نوع، neoformans و var. gattii به ترتیب از سروتیپهای A، D و AD و سروتیپهای B و C تشکیل شدهاند.
- این دو سروتیپ از نظر توزیع جغرافیایی متفاوت هستند: عفونتهای انسانی با سروتیپ A توزیع جهانی دارند درحالیکه عفونتهای سروتیپ D در مناطق جغرافیایی خاصی مانند شمال اروپا شایعتر است.
- neoformans var. neoformans توزیع محدودتری دارد و عفونت ناشی از آن در کشورهای اروپایی از جمله فرانسه، ایتالیا و دانمارک شیوع بیشتری دارد و 30 درصد از سویهها را تشکیل میدهد.
- نئوفرمانس در سراسر جهان یافت میشود، با مدفوع پرندگان (بهویژه کبوترها) مرتبط است و باعث اکثریت قریب به اتفاق عفونتهای انسانی میشود.
- علاوه بر این، عفونتهای ناشی از neoformans var. neoformans بیشتر در ارتباط با بیماران مسنتر، پوست و استفاده از کورتیکواستروئیدها است.
- Cryptococcus neoformans neoformans عامل اصلی بیماری کریپتوکوک در سراسر جهان است. سروتیپ A شایعترین سروتیپ در افراد مبتلا به ایدز است.
- neoformans var. grubii توزیع جهانی دارد و به عنوان عامل ایجاد 95 درصد از کل عفونتهای ناشی از neoformans شناخته میشود.
- از منابع مختلف در طبیعت قابل جداسازی است و به دلیل ارتباط آن با تجمع گوانو پرندگان، به ویژه با فضولات کبوتر، مورد توجه قرار گرفته است.
- این قارچ همچنین از سرگین پرندگان در قفس از جمله قناری، طوطی و باجریگار (مرغ عشق) جداسازی شده است.
- سایر جداسازیهای محیطی neoformans grubii شامل سبزیجات پوسیده، میوهها و آبمیوهها، چوب، محصولات لبنی و خاک است.
- طیف بیماری کریپتوکوک از عفونتهای پوستی محدود شونده تا عفونتهای سیستمیک کشنده متغیر است.
- بیماری سیستمیک با استنشاق ذرات عفونی که منجر به عفونت ریوی اولیه میشود، ایجاد میشود.
- این بیماری میتواند برای مدت زمان طولانی نهفته باقی بماند، اما زمانی که میزبان دچار نقص یا ضعف در سیستم ایمنی شود ظاهر شده و منتشر میشود.
- پس از انتشار، ارگانیسم دارای جهتگیری خاصی به سمت سیستم عصبی مرکزی (CNS) است که اغلب باعث مننژیت کشنده میشود که به آن مننژیت کریپتوکوکی میگویند.
عوامل بیماریزا
-
کپسول
- کپسول، پلیساکاریدی بیرونی که عمدتاً از یک پلیساکارید با وزن مولکولی بالا تشکیل شده است و دارای بستری از واحدهای 1,3-D-mannopyranose با بقایای ß-D-xylopyranosyl و ß-D-glucuronopyranosyl متصل به نئوفورمانس است.کپسول درواقع قویترین عامل بیماریزایی است و به فرار از سیستم ایمنی کمک میکند.
- این کپسول عمدتاً از دو پلیساکارید بزرگ، گلوکورونوکسیلومانان (GXM) و گلوکورونوکسیلومانوگالاکتان (GXMGal) تشکیل شده است.
-
تولید ملانین
- توانایی ارگانیسم برای تشکیل رنگدانه قهوهای تا سیاه روی یک محیط (مانند دانه پرنده یا کافئیک اسید آگار) حاوی ترکیبات دی فنولیک یکی از ویژگیهایی است که سویههای بیماریزا نئوفورمانس را از سویههای غیر بیماریزا و دیگر گونههای کریپتوکوک متمایز میکند.
- در حضور پیشسازهای مناسب، نئوفرمانس ملانین تولید میکند که از تنشهای محیطی از جمله ترکیبات ضدقارچ محافظت میکند.
- ملانین در برابر فاگوسیتوز و مرگ اکسیداتیو توسط ماکروفاژها محافظت میکند و به انتشار خارج ریوی کمک میکند.
-
آنزیمهای خارج سلولی
- لاکازها و فسفولیپاز B در دیواره سلولی قرار دارند و به ترتیب واسطه تشکیل ملانین و یکپارچگی دیواره سلولی هستند.
- فسفولیپاز همچنین به تهاجم قارچی به بافت ریه میزبان و انتشار کمک میکند.
- فسفولیپازها فسفولیپیدها را برای تولید ترکیبات مختلف بیولوژیکی فعال میکنند.
- این آنزیمها ریز محیط عفونت را تغییر میدهند، بنابراین پشتیبانی برای بقای نئوفورمانس در میزبان محسوب میشوند.
-
تغییرات دیواره سلولی و سازگاری با میزبان
- علاوه بر تولید آنزیمها و ساختارهایی که به بقای پاتوژن کمک میکنند، نئوفرمانس همچنین به طور فعال دیواره سلولی خود را در پاسخ به سیگنالهای خاصی که به سمت میزبان هدایت میشود، تنظیم میکند.
- این بازسازی دیواره سلولی نوعی محافظت بیشتر از سطح ایمنی محسوب میشود.
- علاوه بر این، دیواره سلولی به عنوان نقطه اتصال کپسول عمل میکند.
- نئوفرمانس در بین پاتوژنهای قارچی انسان منحصر به فرد است؛ زیرا دیواره سلولی آن از کربوهیدراتهایی از جمله کیتین، کیتوزان و گلوکان تشکیل شده است.
- از آنجایی که دیواره سلولی نئوفرمانس در مقایسه با سایر قارچهای بیماریزا از نظر کیتین و کیتوزان نسبتاً غنی است، قرار گرفتن در معرض کیتین احتمالاً نقش مهمی در پاتوژنز کریپتوکوک و تشخیص ایمنی دارد.
-
وزیکولهای خارج سلولی
- عوامل مختلفی که با پاتوژنز نئوفرمانس مرتبط هستند باید از مکانهای درونسلولی که سنتز در آنها اتفاق میافتد به مکانهایی روی سطح سلول یا خارج از غشای پلاسما منتقل شوند.
- چندین عنصر از مکانیسمهای ترشح غیرمتعارف در بحث کپسول و سایر مولکولهای مرتبط با بیماریزایی دخیل هستند.
- چنین ساختارهایی به عنوان میکرووزیکولها در داخل سلول و همچنین در فضای خارج سلولی شناخته شدهاند.
- میکرووزیکولها حاوی مواد زیادی از جمله پیشسازهای کپسول، ملانین و آنزیمهای ترشح شده هستند.
- میکرووزیکولها که به آنها کیسههای بیماریزا نیز گفته میشود، کاملاً پایدار هستند و به نظر میرسد که میتوانند به صورت موضعی بر روی سطح خارج سلولی میکروارگانیسم عمل کنند یا بر تعامل با سلولهای میزبان تأثیر بگذارند.
- میکرووزیکولهای مشتق شده از کریپتوکوک در فرایند پاتوژنز خود از تغییرات سد خونی مغزی حمایت میکنند که سپس به نئوفورمانس اجازه عبور از سد و ورود به سیستم عصبی مرکزی را میدهد.
پاتوژنز
- روش معمول عفونت کریپتوکوک در انسان استنشاق سلولهای نئوفرمانس آئروسل شده در نتیجه قرار گرفتن در معرض محیط آلوده است.
- دوره کمون ناشناخته است و میتواند هفتهها، ماهها یا حتی بیشتر باشد.
- در افراد سالم عفونت کریپتوکوکوس نئوفورمانس معمولاً از بین میرود یا میتواند برای مدت طولانی در حالت نهفته باقی بماند.
- فعال شدن پاسخهای ایمنی سلولی ذاتی و سازگار در افراد سالم، شدت عفونت را به یک عفونت ریوی بدون علامت و اغلب خود حل شونده محدود میکند.
- برعکس در افراد دچار نقص سیستم ایمنی، انتشار هماتوژن نئوفورمانس از ریهها به سیستم عصبی مرکزی میتواند منجر به مننگوآنسفالیت کریپتوکوک شود که یک عارضه تهدید کننده حیات است و نیاز به مداخله درمانی دارد.
- نئوفرمانس در سلولهای فاگوسیتی میزبان تکثیر میشود که ممکن است از نظر انتشار و حفاظتی مزایایی را برایش به همراه داشته باشد.
- فعل و انفعالات اولیه مخمر با سلولهای میزبان به کمک چسبندگی انجام میشود و همچنین شامل تشخیص اجزای کپسول قارچی توسط است.
- هنگامی که سلولهای چسبنده درونی شدند، به سمت واکوئل حرکت میکنند که در آنجا قادر به زنده ماندن و تکثیر هستند و وضعیت ایمنی میزبان تأثیر زیادی بر نتیجه درونیسازی دارد.
- در انتها بهترین اتفاق ممکن، مرگ قارچ است. یا کریپتوکوک ها ممکن است به تکثیر خود در سلول میزبان ادامه دهند، یا ممکن است توسط یک فرایند لیتیک کشنده برای سلول میزبان یا با یک فرایند غیر لیتیک که هر دو سلول را دستنخورده باقی میگذارد، خارج شود.
- ورود به CNS یک گام کلیدی در پاتوژنز کریپتوکوکوس نئوفورمانس است.
- گزارشها و مطالعات مختلف نشان میدهد که کریپتوکوکهای درونی و آزاد میتوانند از سد خونی مغزی عبور کرده و به مغز برسند که این عمل یا از طریق ترانس سیتوز و سلولهای اپیتلیال و یا از فضای بین آنها به کمک شکستن اتصالات محکم و یا ترکیبی از هر دوی این روشها اتفاق میافتد.
تظاهرات بالینی کریپتوکوکوس نئوفرمانس
-
کریپتوکوکوزیس ریوی
- تا 30 درصد از افراد دارای سیستم ایمنی قابل قبول، پس از استنشاق نئوفورمانس هیچ علامتی ندارند و عفونت آنها تا زمانی که به سایر اندامها سرایت نکند ناشناخته باقی میماند.

- علاوه بر این، بیماران مبتلا به بیماری مزمن ریوی مانند برونشیت و برونشکتازی نیز ممکن است کلونیزاسیون بدون علامت داشته باشند و کریپتوکوکوس در خلط آنها در طی سالیان متمادی وجود داشته و قابل جداسازی باشد.
- قرار گرفتن در معرض محیط آلوده به نئوفورمانس منجر به کریپتوکوکوزیس تحت بالینی میشود و افراد عادی ممکن است یک پنومونی خود محدود شونده همراه با حساسیت را تجربه کنند.
- اکثر عفونتهای اولیه هیچ علائم تشخیصی ندارند و معمولاً فقط با عکسبرداری معمولی با اشعه ایکس از قفسه سینه مشخص میشوند.
- تظاهرات بالینی نیز به ویژگیهای سلامت ایمونولوژیک بیماران بستگی دارد.
- برخلاف افراد عادی، اکثر بیماران دچار نقص ایمنی علائمی از جمله تب، درد قفسه سینه، کاهش وزن، تنگی نفس، تعریق شبانه و سرفه را نشان میدهند.
- شایعترین یافتههای رادیولوژیکی ضایعات ندولار کاملاً مشخص، غیرکلسیفیه، منفرد یا چندگانه هستند.
- از سوی دیگر، یافتههای کمتر شایع شامل ارتشاحهای غیرمشخص تا تودهمانند، بزرگ شدن غدد لنفاوی ناف و مدیاستن، افیوژن پلور و کاویتاسیون است.
- در مواردی که عفونتهای اولیه برطرف نمیشوند، اغلب منجر به کریپتوکوکوزیس ریوی تهاجمی میشود که بیشتر منجر به پنومونی مزمن میشود که بهکندی طی چندین سال پیشرفت میکند.
- کریپتوکوکوزیس مزمن ریوی نیز خطر انتشار به سیستم عصبی مرکزی را افزایش میدهد.
-
عفونتهای CNS (مننژیت کریپتوکوکی)
- کریپتوکوکوس نئوفرمانس همچنان یکی از علل مهم عوارض و مرگومیر است و به عنوان شایعترین مایکوزیس سیستم عصبی مرکزی (CNS) در بیماران دچار نقص ایمنی، به ویژه بیماران مبتلا به ایدز در نظر گرفته میشود.
- انتشار عفونت از ناحیه ریوی به مغز و مننژها شایعترین تظاهرات بالینی است که توسط کریپتوکوکوس نئوفورمانس نشان داده میشود و شامل مننژیت، مننژوانسفالیت یا کریپتوکوکومای در حال گسترش است.
- مننژیت شایعترین شکل بالینی است که تا 85 درصد از کل موارد را تشکیل میدهد.
- علائم معمولاً بهآرامی در طی چند ماه ایجاد میشوند و در ابتدا شامل سردرد و به دنبال آن خوابآلودگی، سرگیجه، تحریک پذیری، حساسیت به نور، گیجی یا تغییر در رفتار، حالت تهوع، استفراغ، سفتی گردن و مشکلات عصبی کانونی مانند آتاکسی است.
- سردرد شایعترین علامت تظاهر کننده است و درد مبهم، دوطرفه و منتشر است.
- تب اغلب تا اواخر دوره عفونت در حداقل مقدار است یا تقریباً وجود ندارد.
- در مراحل بعدی عفونت، کاهش حدت بینایی و کما نیز ممکن است رخ دهد.
- مننژوآنسفالیت ناشی از تهاجم به قشر مغز، ساقه مغز و مخچه یک عفونت سریع و غیرمعمول است که اغلب در مدت کوتاهی منجر به کما و مرگ میشود.
- کریپتوکوکوم موجودیت نادری است که اغلب با تودههای تومور مانند موضعی مشخص میشود که معمولاً در نیمکرههای مغزی یا مخچه یا بهندرت در نخاع یافت میشود.
- علائم با افزایش توده داخل جمجمهای مطابقت دارد و شامل سردرد، خوابآلودگی، تهوع، استفراغ، تغییرات ذهنی، مشکل تکلم، دوبینی، عدم ثبات در راه رفتن، کما، فلج و همی پارزی است.
-
کریپتوکوکوزیس جلدی (پوستی)
- گسترش هماتوژن نئوفورمانس باعث ایجاد ضایعات پوستی در 10 تا 15 درصد از بیماران مبتلا به عفونت کریپتوکوکوزیس منتشر میشود.
- ضایعات جلدی تظاهرات بالینی شایع در افراد آلوده به اچآیوی مبتلا به کریپتوکوکوزیس است و به عنوان دومین محل شایع کریپتوکوکوزیس منتشر محسوب میشود.
- کریپتوکوکوزیس جلدی اولیه گاهی به شکل ضایعات زخمی یا سلولیت بهخصوص در بیماران مبتلا به سرکوب سیستم ایمنی رخ میدهد.
- عفونتهای پوستی ثانویه در بیماران مبتلا به کریپتوکوکوزیس منتشر رخ میدهد و اغلب نشان دهنده پیشآگهی ضعیف درمانی است.
- در برخی موارد این ضایعات اولین نشانه بالینی عفونت هستند و اغلب روی صورت و پوست سر قرار دارند، اما ممکن است روی تنه یا اندامها نیز ایجاد شوند.
- ضایعات معمولاً به صورت پاپولهای کوچک (گرههای منفرد یا چندگانه) شروع میشوند که متعاقباً زخمی میشوند، اما ممکن است به صورت آبسه، گرههای اریتماتوز یا سلولیت نیز ظاهر شوند.
- ضایعات اغلب در سروگردن ایجاد میشوند و ممکن است به صورت پاپول، ندول، پلاک، زخم، آبسه و پلاک زخمی پوستی ظاهر شوند.
- زخم مقعد نیز ممکن است رخ دهد.
-
کریپتوکوکوزیس چشمی
- علائم چشمی کریپتوکوکوزیس معمولاً نادر است و معمولاً نتیجه انتشار است.
- شایعترین تظاهرات کریپتوکوکوزیس چشمی شامل ادم پاپی (تورم دیسک بینایی) و آتروفی بینایی به دلیل افزایش فشار داخل جمجمه است.
-
کریپتوکوکوزیس استخوان (استئومیلیت)
- استئومیلیت در 5 تا 10 درصد از بیماران مبتلا به کریپتوکوکوزیس منتشر رخ میدهد و ممکن است برجستگیهای استخوانی، استخوانهای جمجمه و مهرهها را درگیر کند.
- اکثر بیماران با یک ضایعه مجزا مراجعه میکنند. ستون فقرات شایعترین محل درگیری با بیمارانی است که از درد موضعی و حساسیت بافت نرم در محل آسیبدیده شکایت دارند.
- ضایعات لیتیک بوده و علائم درد مبهم در هنگام حرکت گزارش شده است.
- رادیوگرافی ضایعات استئولیتیک کاملاً مشخص و بدون اسکلروز حاشیهای یا تغییر پریوست است و از سیتیاسکن میتوان برای تعیین میزان درگیری استخوان استفاده کرد.
- موارد گاه به گاه آرتریت نیز گزارش شده است که بیشتر مفصل زانو را درگیر میکند.
-
سایر اشکال کریپتوکوکوزیس
- در بیماران مبتلا به عفونتهای منتشر، کریپتوکوکوس نئوفورمانس اغلب از ادرار قابل جداسازی است.
- گاهی ممکن است علائم پیلونفریت یا پروستاتیت در بیماران مشاهده شود.
- علاوه بر این، سایر اشکال نادر کریپتوکوکوزیس شامل ضایعات قشر آدرنال، اندوکاردیت، هپاتیت، سینوزیت و ضایعات موضعی مری است.
تشخیص آزمایشگاهی
-
نمونههای بالینی
مایع مغزی نخاعی (CSF)، بافت بیوپسی شده، خلط، شستشوی برونش، چرک، خون و ادرار.
-
میکروسکوپی مستقیم
- لایه مرطوب نازک زیر یک پوشش با استفاده از جوهر هندی برای ترشحات و مایعات بدن برای نشان دادن سلولهای مخمر محصور شده.
- قبل از رنگآمیزی جوهر هند، خلط و چرک تحت آماده سازی KOH 10% قرار میگیرند.
- در برشهای بافتی، برای نشان دادن کپسول پلیساکارید، اغلب از PAS (رنگآمیزی اسید- شیف پریودیک)، GMS (متنامین گروکوت) ، H&E و موسیکارمین استفاده میشود.
- سلولهای مخمر کروی تا تخمی شکل و جوانهزده که توسط کپسولهای ژلاتینی پهن احاطه شدهاند باید بررسی شوند.
- نمونههای خلط مثبت باید به عنوان موارد بالقوه در نظر گرفته شوند، بااینحال کریپتوکوکوس ممکن است در ترشحات تنفسی به عنوان ساپروفیت وجود داشته باشد.
- اساساً همه بیماران با میکروسکوپی مثبت برای کریپتوکوک ها، باید از نظر بیماری منتشره، به ویژه با کشت و تشخیص آنتیژن بررسی شوند.
-
کشت
- ارگانیسم در محیطهای میکروبیولوژیکی استاندارد به خوبی رشد میکند.
- در دمای 30-35 درجه سانتیگراد بهترین رشد را دارد و در موارد مشکوک، انکوباسیون پلیتها تا 2 هفته توصیه میشود.
- نمونهها را روی محیطهای جداسازی اولیه مانند سابورو دکستروز آگار تلقیح کنید.
- مشاهده خواهید کرد که کلنیهای ژلاتینی شفاف و صاف بعداً بسیار مخاطی و کرم رنگ میشوند.
-
سرولوژی
- روش انتخابی یا مطمئنترین روش برای تشخیص بیماران مبتلا به مننژیت کریپتوکوکی، تشخیص آنتیژن پلیساکارید کپسولی کریپتوکوک در مایع نخاعی است.
- در بیماران مبتلا به ایدز مبتلا به کریپتوکوکوزیس، آنتیژن کریپتوکوک در سرم تقریباً در 100 درصد موارد قابل تشخیص است. با این حال، در بیماران غیر ایدزی، تشخیص آنتیژن در سرم حساسیت کمتری دارد و تنها حدود 60 درصد از بیماران مبتلا به کریپتوکوکوزیس مثبت گزارش شدهاند.
- آزمایشاتی مانند آگلوتیناسیون ذرات لاتکس (LPA) و سنجش ایمونوسوربنت متصل به آنزیم (ELISA) برای تشخیص آنتیژن در نمونههای سرم، CSF، ادرار و مایع BAL به بازار عرضه شده است.
- این آزمایشات منحصر و خاص هستند. با این حال، اگر بار ارگانیسم کم باشد یا اگر ارگانیسمها به خوبی کپسوله نشده باشند، نتایج منفی کاذب میتواند رخ دهد.
- تیتر آنتیژن سرم 1:8 یا بیشتر به عنوان شواهد احتمالی قوی عفونت نئوفورمانس در نظر گرفته میشود. نتیجه منفی آزمایش آنتیژن سرم، تشخیص کریپتوکوکوزیس را رد نمیکند، به خصوص اگر تنها یک نمونه آزمایش شده باشد و بیمار علائمی مطابق با عفونت داشته باشد.
- سطح آنتیژن در CSF اغلب با درمان کاهش مییابد، اما آزمایش میتواند برای چند هفته مثبت بماند.
- آنتیبادیهای نئوفورمانس را اغلب میتوان در بیماران مبتلا به عفونت موضعی یا سابقه عفونت در گذشته شناسایی کرد، اما به ندرت در بیماران مبتلا به عفونت مننژیال درمان نشده یا منتشر دیده میشود.
درمان کریپتوکوکوس نئوفرمانس
- در بیماران مبتلا به عفونتهای بدون علامت یا عفونتهای ریوی خفیف تا متوسط، درمان معمولاً با فلوکونازول است.
- در بیماران مبتلا به عفونت شدید ریه یا عفونت در سیستم عصبی مرکزی (مغز و نخاع)، درمان اولیه توصیه شده آمفوتریسین B در ترکیب با فلوسیتوزین است. پس از آن، فلوکونازول برای مدت طولانی برای از بین بردن عفونت توصیه میشود.
مدیریت و پیشگیری
- همه بیماران مبتلا به کریپتوکوکوزیس، به غیر از تعداد کمی که سیستم ایمنی قابل قبولی دارند، نیاز به درمان دارند.
- انتخاب درمان هم به محل درگیری آناتومیک و هم به وضعیت ایمونولوژیک میزبان بستگی دارد.
- پروفیلاکسی اولیه با ایتراکونازول یا فلوکونازول ممکن است در بیماران HIV مثبت با تعداد CD4 کمتر از 100 سلول در میکرولیتر مؤثر باشد. با این حال، پیشگیری معمول ضدقارچی به دلیل نادر بودن بیماری کریپتوکوک، تداخلات دارویی بالقوه، هزینه بالا، عدم بقای خاصیت پیشگیری و امکان ایجاد مقاومت دارویی، توصیه نمیشود.
- با این حال، مشخص شد که فلوکونازول به عنوان پیشگیری اولیه، چه قبل و چه در طول درمان اولیه، ایمن و مؤثر است.
- پروفیلاکسی ثانویه کریپتوکوکوزیس شامل درمان نگهدارنده با فلوکونازول به عنوان اولین انتخاب برای جلوگیری از عود عفونت است و ممکن است در بیمارانی که به درمان ضد رتروویروسی (ART) پاسخ میدهند، قطع شود.
- این امر نشان میدهد که یک نیاز فوری بهداشت عمومی و بشردوستانه برای انجام کارآزماییها و تعیین اینکه آیا پیشگیری ضدقارچی نقشی در پیشگیری از کریپتوکوکوزیس و بهبود بقای افراد آلوده به HIV در کشورهای در حال توسعه با بار بالای این بیماری، وجود دارد یا خیر.
همچنین بخوانید:
- باسیلوس سرئوس: زیستگاه، ساختار، درمان و پیشگیری
- محیط کشت چیست؟ آشنایی با انواع محیط کشت و کاربرد
- اکتینوباکتر چیست؟ خصوصیات، اکولوژی و مورفولوژی
- استافیلوکوکوس اورئوس چیست؟
- استافیلوکوکوس اپیدرمیدیس چیست؟
- عفونت استافیلوکوکی چیست؟
مترجم: مریم محجوب




خیلی خوب بود پیروز باشید
برای شناسایی باکتری لیستریا مونوسیتوژنز از شیر چه محیط کشتی مناسب است؟
Fraser broth
كسـفورد اگار
University of vermont media